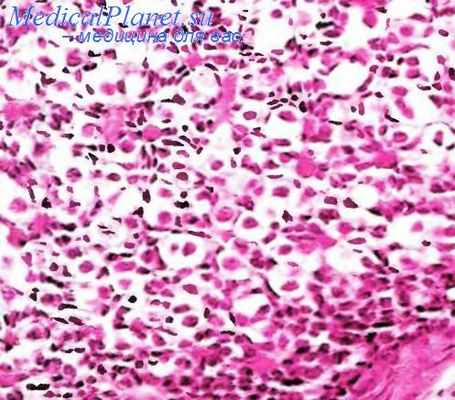
Гонадобластома яичника

Струма яичника. Карциноид яичника. Гонадобластома яичников.
Добавил пользователь Владимир З. Обновлено: 27.01.2026
Занимают второе место среди опухолей женских половых органов. Доброкачественные встречаются у 80%, злокачественные - у 20% больных. Опухоли яичников наблюдают у больных в любом возрасте, но чаще всего - от 40 до 60 лет.
Рак яичников развивается обычно на фоне предсуществующих доброкачественных опухолей.
Международная классификация злокачественных опухолей яичников (FIGO)
I - стадия - опухоль ограничена яичником
Iа стадия - опухоль ограничена одним яичником. Асцита нет
Ia (i) стадия - нет разрыва капсулы
Ia (ii) стадия - разрыв капсулы
Ib стадия - опухоль ограничена двумя яичниками. Асцита нет
Ib (i) стадия - нет разрыва капсулы
Ib (ii) стадия - разрыв капсулы
Ic стадия - опухоль ограничена одним или двумя яичниками, есть асцит, который содержит злокачественные клетки
Ic (i) стадия - нет разрыва капсулы
Ic (ii) стадия - разрыв капсулы
II стадия - опухоль вовлекает один или оба яичника с распространением по тазовым органам
IIa стадия - распространение процесса на матку, трубы или другой яичник
IIb стадия - распространение по другим тканям таза
III стадия - опухоль вовлекает один или оба яичника с широко распространенными интраперитонеальными метастазами
IV стадия - опухоль вовлекает один или оба яичника с отдаленными метастазами
Специальная категория - Неоперабельные больные, у которых, вероятно, имеется рак яичника
Примечание. Наличие асцита не влияет на определение стадии. «Разрыв» - указывает пролиферацию на поверхности или спонтанный разрыв и не относится к разрыву во время операции.
По локализации: 1. Первичные односторонние. 2. Первичные двухсторонние. 3. Метастатические односторонние. 4. Метастатические двухсторонние. 5. Распространение в полости малого таза. 6. Распространение по всей брюшной полости.
По типам опухолевого роста: 1. Эвертирующий. 2. Инвертирующий. 3. Смешанный
- «Эпителиальные» опухоли
- Серозные опухоли
- Доброкачественные:
- цистаденома и папиллярная цистаденома
- поверхностная папиллома
- аденофиброма и цистадено-фиброма
- цистаденома и папиллярная цистаденома
- поверхностная папиллома
- аденофиброма и цистаденофиброма
- аденокарцинома, папиллярная аденокарцинома и папиллярная цистаденокарцинома
- поверхностная папиллярная карцинома
- злокачественная аденофиброма и цистаденофиброма
- Доброкачественные:
- цистаденома
- аденофиброма и цистаденофиброма
- цистаденома
- аденофиброма и цистаденофиброма
- аденокарцинома и цистаденокарцинома
- злокачественная аденофиброма и цистаденофиброма
- Доброкачественные:
- аденома и цистаденома
- аденофиброма и цистаденофиброма
- аденома и цистаденома
- аденофиброма и цистаденофиброма
- карцинома:
- аденокарцинома;
- аденоакантома;
- злокачественная аденофиброма и цистаденофиброма
- Доброкачественные: аденофиброма
- Пограничные (потенциально низкой степени злокачественности)
- Злокачественные: карцинома и аденокарцинома
- Доброкачественные
- Пограничные (пограничной злокачественности)
- Злокачественные
- Доброкачественные
- Пограничные (пограничной злокачественности)
- Злокачественные
- Гранулезо-стромально-клеточные опухоли
- Гранулезоклеточная опухоль
- Группа теком-фибром
- текома
- фиброма
- неклассифицируемые
- Высокодифференцированные
- тубулярная андробластома; опухоль из клеток Сертоли
- тубулярная андробластома с накоплением липидов; опухоль из клеток Сертоли с накоплением липидов (липидная фолликулома Лесена)
- опухоль из клеток Лейдига;
- опухоль из хилюсных клеток
- Дисгерминома
- Опухоль эндодермалыюго синуса
- Эмбриональная карцинома
- Полиэмбриома
- Полионэпителиома.
- Тератомы
- Зрелые:
- солидные
- кистозные:
- дермоидная киста;
- дермоидная киста с малигнизацией
- струма яичника карциноид струма яичника и карциноид другие
- Чистая (без примеси других форм)
- Смешанная с дисгерминомой и другими формами герминогенных опухолей
- Лютеома беременности
- Гиперплазия стромы яичника и гипертекоз
- Массивный отек яичника
- Единичная фолликулярная киста и киста желтого тела
- Множественные фолликулярные кисты (поликистозные яичники)
- Множественные лютеинизированные фолликулярные кисты и желтые тела
- Эндометриоз
- Поверхностные эпителиальные кисты включения (терминальные кисты включения)
- Простые кисты
- Воспалительные процессы
- Параовариальные кисты
Клиническая картина и симптоматика. Злокачественные опухоли яичников, в особенности в начале заболевания, имеют незначительные клинические проявления: наличие у больной «немотивированной» слабости, понижение трудоспособности, чувство дискомфорта, неприятные ощущения внизу живота, нелокализованная боль в животе различного характера, ускоренная СОЭ. При наличии одновременно опухолевого образования в области придатков можно думать о раке яичников.
Диагностика. В анамнезе часто позднее наступление менструации (в 15 - 16 лет) и первичное бесплодие, односторонняя овариоэктомия, субтотальная и лучевая кастрация.
Бимануально определяется опухоль придатков, в запущенном состоянии - с бугристостью в заднем своде.Нередко появляется асцит и гидроторакс. Цитологическое исследование эвакуированной жидкости позволяет обнаружить комплексы атипичных клеток, что облегчает установление диагноза, особенно при диссеминированных формах «малого» рака яичника.
Брюшностеночно-ректо-вагинальное исследование следует производить при опорожненном мочевом пузыре и толстом кишечнике, а также после эвакуации асцитической жидкости, так как это дает более полную информацию о состоянии органов малого таза и брюшной полости. При пальпации живота следует обращать внимание на область пупка, эпи- и мезо-гастрия (метастатические поражения). Для определения степени распространенности процесса (прорастание в соседние органы, их сдавление и наличие метастазов) показаны рентгеноскопия и рентгенография органов грудной и брюшной полости, цистоскопия, урография, лимфография, гистерография на фоне пиевмоперитонеума, вазография. Дополнительные методы диагностики: эндокринологическое исследование - определение гормонального зеркала, биохимическое исследование крови (осадочная реакция на рак; реакция связывания агара; сывороточная реакция Хакима и определение общей активности лактатдегидрогеназы). Иммунологические исследования - реакция лизиса культуры Вас. Megateriam и сыворотки крови больных.
В тех случаях, когда все диагностические возможности исчерпаны и тем не менее остается сомнение в наличии опухоли яичников, больная подлежит обязательному диагностическому чревосечению.Методы лечения опухолей яичников
Наиболее обоснованным является комплексный метод, то есть рациональное сочетание хирургического вмешательства, химио- и гормонотерапии, а в некоторых случаях - целенаправленной лучевой терапии. План лечения больной со злокачественными опухолями яичников должен быть составлен индивидуально, на длительный период с учетом стадии заболевания, возраста, общего состояния больной, предшествующего лечения. .
Хирургический метод. При наличии у больной подвижных опухолей лечение начинают с оперативного вмешательства. Объем операции зависит от характера опухоли и степени распространения ее. При ретенционных образованиях (кистах) допускается резекция пораженной части яичника. В пре- и менопаузальном периоде при удалении кистомы яичника целесообразно удалять и второй неизмененный яичник. При подозрении на озлокачествление опухоли (эвертирующий рост, диссеминация по брюшине, гистологическое заключение экспрес-биопсии о наличии прилиферирующей кистомы) тактика оперативного вмешательства идентична той, которая принята для злокачественных опухолей яичников, а именно: надвлагалищная ампутация матки (или экстирпация в зависимости от распространенности процесса) с опухолями придатков и резекция сальника на уровне поперечной ободочной кишки. При обнаружении единичных имплантатов на париетальной или висцеральной брюшине их удаляют (при необходимости - с резекцией части пораженного органа).
Исключение составляют тератогенные опухоли яичников у девушек, при которых поражен, как правило, один яичник. В этих случаях допустимо удаление только пораженного яичника.Ряду больных произвести радикальную операцию из-за распространенности процесса не представляется возможным. Хирургическая тактика при запущенных стадиях рака яичников отличима от общеонкологических принципов. Бережное удаление хотя бы основной массы опухоли, резекция пораженного сальника значительно улучшают результаты послеоперационной химиотерапии. При пробных чревосечениях необходимо взять кусочки ткани из опухоли для гистологического исследования. В конце операции в брюшную полость вводят дренажную трубку для введения химиопрепаратов.
Химиотерапия. При наличии у больной неподвижных опухолей придатков матки и при технических трудностях в удалении их необходимо начинать лечение с предоперационного курса химиотерапии. Предпочтение следует отдавать внутри-брюшному способу введения, так как это позволяет подвести препарат непосредственно к очагу поражения. При наличии асцитической жидкости ее удаляют, и химиопрепараты вводят через постоянную дренажную трубку. При безасцитных формах рака яичников препараты можно вводить в брюшную полость путем прокола пупочного кольца. При наличии выпота в плевральной полости препараты вводят внутриплеврально после эвакуации жидкости.
Курсовая доза химиопрепаратов определяется в зависимости от состояния периферической крови и динамики регрессии опухоли. Разовая доза - в зависимости от путей введения. Наиболее эффективны - бензотэф, ТиоТЭФ и циклофосфан.
В брюшную или плевральную полость вводят по 48 мг бензотэфа, 40 - 60 мг ТиоТЭФа или 600 мг циклофосфана. Введение повторяют через день. После 5 введений оценивается клинический эффект химиотерапии. При хорошем клиническом эффекте и удовлетворительном состоянии больной предоперационный курс продолжают, доведя суммарно дозу бензотефа до 360 - 600 мл, ТиоТЭФа до 300 - 400 мл, циклофосфана до 3,5 - 5,0 г. Трубка может находиться в брюшной полости до 3 нед. После извлечения трубки препараты вводят внутривенно: бензотэф по 24 мг, ТиоТЭФ по 20 мг, циклофосфан по 200 - 400 мг.
Учитывая поражение парааортальных лимфатических узлов при раке яичников, можно рекомендовать эндолимфатический метод введения химиопрепаратов при разовой дозе 80 - 100 мг ТиоТЭФ, 160 - 180 мг бензотэфа, в каждую сторону.
Во время операции в брюшную полость следует вводить при диссеминированных формах рака яичников по 48 мг бензотэфа или по 40 - 60 мг ТиоТЭФа.В послеоперационный период независимо от объема операции химиотерапию проводят при всех стадиях рака яичников, а также при пролиферирующих кистомах яичников. Разовые дозы те же, что и при проведении предоперационного курса. При нерадикальных операциях препараты вводят в максимальных дозах, но не более 600 мг бензотэфа, 500 мг ТиоТЭФа и 8 - 10 г циклофосфана и только при функциональном состоянии печени и кроветворных органов.
Лучевая терапия оправдана лишь при оставлении в малом тазу или брюшной полости единичных опухолевых инфильтратов или метастатических формах дисгермином. В этих случаях лечение дополняется дистанционной терапией в дозе 3000 рад на очаг или по 1200 - 1500 рад, если есть несколько очагов на маркированные танталовыми скобками участки для проведения целенаправленного лучевого воздействия, суммарно не более 6000 рад.
Гормональное лечение ведет к повышению сопротивляемости организма. В комплексном лечении используют - 5 - 10% тестостерона пропионат по 50 мг до 3 - 5 г на курс лечения. Применяют также препараты пролонгированного действия - тестенат 20% по 1 мл 1 раз в неделю или сустанон – 25% по 1 мл 1 раз в месяц.
Профилактика рака яичников заключается в выявлении лиц с предопухолевым заболеванием: с сомнительным диагнозом узловатой фибромиомы; длительное время лечившихся по поводу хронического воспаления придатков матки; с опухолями в малом тазу неясной локализации; перенесшие одностороннюю овариоэктомию, субтотальную или лучевую кастрацию; с первичной функциональной недостаточностью яичников.
Струма яичника. Карциноид яичника. Гонадобластома яичников.
Струма яичника. Карциноид яичника. Гонадобластома яичников.
Струма яичника. Термин «струма яичника» относится к тем тератомам, в которых тиреоидная ткань преобладает или составляет значительный компонент опухоли. Струма встречается редко. Большинство их (60-70%) имеет вид четко отграниченного узла, расположенного в стенке или перегородке доброкачественной кистозной тератомы. Реже (в 10% случаев) локализуется в стенке муцинозной кистомы. Примерно 20-30% она состоит лишь из ткани щитовидной железы. «Чистая» струма почти всегда односторонняя, неправильной формы. На разрезе опухоль плотной, местами мягкой или мясистой консистенции, солидного и солидно-мелкокистозного строения.
Кисты разной величины, выполнены коричневым или желтовато-белым содержимым. Струма яичника содержит йод, но в меньшем количестве, чем нормальная щитовидная железа. В некоторых случаях отмечены признаки гипертиреоза. Морфологически етрума идентична строению ткани щитовидной железы, состоит из множества полостей, содержащих коллоид и выстланных кубическим эпителием. Малигнизированная сгрума яичника встречается редко.
Карциноид возникает в 8 10 раз реже струмы яичника, наиболее часто из аргентаффинных клеток кишечного эпителия зрелой тератомы, реже респираторного эпителия ее. Примерно в половине наблюдений у больных отмечают карщшоидный синдром. Большинство карциноидов имеет вид отграниченного узла, расположенною в стенке дермоидной кисты или муцинозной опухоли. На разрезе карциноид преимущественно желтого или оранжевого цвета. «Чистые» карциноиды (встречаются очень редко) обычно односторонние, того же цвета, что и в тератоме небольшого размера. Гистологически карциноид идентичен карциноидам желудочно-кишечного тракта и дыхательных путей.
Клетки карциноидных опухолей располагаются в виде тяжей, островков, столбиков. Островки клеток, обычно имеющие солидный характер, более свойственны карциноиду яичника. Клетки карциноида в опухолях из сочетания струмы и карциноида имеют преимущественно трабекулярный характер расположения. До сих пор не доказано, что эти опухоли являются клинически злокачественными.
Эпидермоидная киста яичника встречается очень редко, обычно небольшой величины, выстлана плоским многослойным эпителием с ясно выраженными слоями из шиповатых и зернистых клеток. Иногда обнаруживают тонкий роговой слой. Какие-либо другие ткани, в том числе придатки эпидермиса, в кистах отсутствуют.
Смешанные герминогенные опухоли встречаются относительно часто, состоят из одного или более приведенных выше типов опухолей, например эмбриональной карциномы, дисгерминомы. хорионэпителиомы и тератомы.
![карциноид яичника]()
Карциноид яичника
Гонадобластома яичников.
Гонадобластома (гоноцитома, дисгенетическая гопадома, опухоль дисгенетических юнад, опухоль Скалли) редкая опухоль, размером от 1 х 2 мм до 10 см. Двусторонняя локализация отмечается в 1/3 всех случаев. Опухоль обычно округлой формы, нлотноэластической, мягкой или очень твердой консистенции при ее обызвествлении. На разрезе она серо-розового цвета, иногда с участками желтоватого или оранжевого цвета. При обширном обызвествлении поверхность разреза ее имеет зернистый вид. При приготовлении срезов на месте очагов обызвествления оказываются пустоты. Гонадобласгома состоит из больших зародышевых клеток, сходных с клетками дисгерминомы, и более мелких клеток, напоминающих клетки гранулезы и сустеноциты, а также участков обызвествления и гиалиновых телец.
В некоторых наблюдениях гонадобластома представлена лишь небольшими фокусами в опухоли, имеющей характер дисгерминомы. Клетки гранулезы и сустеноциты могут быть расположены как вокруг округлых полостей, содержащих ШИК-положительный материал, напоминая микрофолликулярный вариант гранулезоклеточной опухоли, так и по периферии гнездных скоплений зародышевых клеток, иногда они окружают отдельные зародышевые клетки в виде венчика. Клеточные гнезда, имеющие толстую базальную мембрану, отграничены различным количеством стромы, имеющей сходство с овариальной сгромой, в которой более чем в половине наблюдений встречаются эозинофильиые клетки лютеинового шпа или гландулоциты. У больных старше 15 лет они встречаются в 2 раза чаще. В 34— 50% гонадобластома сочетается с дисгерминомой, редко - с опухолью эндодермального синуса, зрелыми и незрелыми солидными тератомами, хорионэнигелиомой.
При обнаружении в дисгерминоме очагов обызвествления необходимо исследовать дополнительно вырезанные кусочки ткани, а если новообразование небольших размеров, то и всю опухоль, так как наличие в ней петрификатов не позволяет в таких случаях исключить возможность сочетания дисгерминомы с гонадобластомой. Примерно в половине наблюдений гонадобластома возникает в половых железах, тип которых (яичник или семенник) определить невозможно из-за полного замещения их опухолью. У 1/3 больных гонадобластома возникает в «штрих-гонадах», а у остальных в незрелых атрофических или дисгенетических яичках. Возраст больных с гонадобластомой 6—28 лет.
Больные с женским фенотипом составляют примерно 85% всех гонадобластом. Больные с признаками вирилизма составляют более половины всех больных с женским фенотипом. Подавляющее большинство их в возрасте 15 лет и старше.
Больные с гонадобластомой и мужским фенотипом составляют около 15% всех гонадобластом. Гонадобластома обычно рассматривается как доброкачественная опухоль. Однако зародышевые клетки могут иногда иметь признаки злокачественности, что проявляется в митотической активности и/или локальной инвазии их.
При сочетании гонадобластомы с дисгерминомой прогноз для больного более благоприятный, чем при дисгерминоме в отсутствие гонадобластомы; в отличие от дисгерминомы метастазы опухоли при сочетании гонадобластомы и дисгерминомы появляются позднее и реже.
Кроме того, в яичниках встречают очень редко опухоли мягких тканей, более обычные для других органов и тканей, чем для яичника. Они возникают из тех его элементов (мышечные клетки, кровеносные или лимфатические сосуды и др.), которые не выполняют специфические функции этого органа (лейомиома, гемангиома, лейомиосаркома, гемангиоэндотелиома и ряд других доброкачественных и злокачественных опухолей). Макро- и микроскопическая характеристика этих опухолей отличается особенностями, свойственными им при локализации в других органах и тканях. Среди других опухолей следует упомянуть лимфангиому. Она описана менее чем у 10 больных с односторонней локализацией, размером до б см, редко более крупной. В дифференциально-диагностическом отношении следует принимать во внимание аденоматоидную опухоль яичника, которая, как правило, бывает мелкой, односторонней и бессимптомной.
![Гонадобластома яичника]()
Гонадобластома яичника
Информация на сайте подлежит консультации лечащим врачом и не заменяет очной консультации с ним.
См. подробнее в пользовательском соглашении.Опухоли яичников (стр. 11 из 14)
Применение эхографии с ЦДК может способствовать уточнению диагностики. Эхографические картины отражают смешанное, кистозно-солидное строение незрелой тератомы с неровными нечеткими контурами. Подобно всем злокачественным вариантам опухолей незрелая тератома имеет хаотическое внутреннее строение с выраженной неоваскуляризацией. При ЦДК визуализируется выраженная мозаичная картина с турбулентным кровотоком и преимущественно центрально расположенными и артериовенозными шунтами. Максимальная систолическая скорость кровотока понижает индексы периферического сопротивления (ИР ниже 0,4).
Лечение хирургическое. Допустимы надвлагалищная ампутация матки с придатками и удаление сальника. Незрелые тератомы малочувствительны к лучевой терапии, но иногда реагируют на комбинированную химиотерапию. Прогноз неблагоприятный.
В). Монодермальные тератомы.
Струма яичника - это тератома, которая исключительно или в значительной мере состоит из ткани щитовидной железы. Струма яичника встречается у 40-60-летних женщин, хотя изредка поражаются женщины других возрастных групп. Рост опухоли иногда сопровождается асцитом (по типу синдрома Мейгса) и очень редко - симптомами тиреотоксикоза. Струма яичника - обычно односторонняя опухоль, хотя иногда сочетается с дермо-идной кистой в противоположном яичнике. Макроскопически наружная поверхность струмы гладкая, консистенция ее ткани эластическая. Поверхность разреза - коричневатая, коричневато-красная, иногда с выраженным зеленым оттенком, изредка она содержит заполненные коллоидом кисты. Под микроскопом в опухоли встречаются очаги нормальной ткани щитовидной железы, а также зоны, имеющие строение зоба. Очень часто обнаруживаются кистозные полости, иногда лишенные выстилки. Нередки кровоизлияния, ксантоматоз, склероз, отложения солей кальция, очаги остеогенеза. Злокачественная струма яичника чаще всего имеет картину папиллярного рака. Злокачественную струму яичника следует дифференцировать от крайне редкой патологии - метастаза рака щитовидной железы в яичник.
Карциноид по строению обычно соответствует аналогу другой локализации. Первичный карциноид яичников почти в 90% случаев связан с тератомой этого парного органа. Различают несколько типов карциноида: инсулярный, трабекулярный, струмальный типы и карциноид из бокаловидных клеток.
Нейроэктодермальные опухоли являются структурными аналогами соответствующих новообразований центральной нервной системы. Обычно это кистозно-солидная опухоль, достигающая 20 см в диаметре и более. Ее наружная поверхность может быть покрыта сосочками. Солидные участки имеют мягкую консистенцию, желтовато-серый, коричневый или розовый цвет. В опухоли имеется много очагов кровоизлияний и некрозов. Крайне редко встречается двустороннее поражение. По микроскопическому строению эта опухоль идентична соответствующим аналогам в центральной нервной системе.
Струмальный карциноид - опухоль, содержащая ткань щитовидной железы и карциноидные клетки, т.е. клетки эндодермального и нейроэктодермального происхождения. Кроме того, описаны опухоли яичника, секретирующие АКТГ-подобные пептиды и протекающие с клинической картиной синдрома Иценко-Кушинга, а также опухоли, секретирующие паратгормон и сопровождающиеся клинической картиной гиперкальциемии. Лечение карциноида яичника хирургическое.
1.7 Смешанные злокачественные герминогенные опухоли
Смешанные злокачественные герминогенные опухоли составляют примерно до 10% от всех злокачественных герминогенных опухолей яичника. Для правильного планирования химиотерапии особенно важно выделение чистой дисгерминомы и дисгерминомы в сочетании с другими злокачественными компонентами: опухолью эндодермального синуса, эмбриональным раком и хориокарциномой.
V. Гонадобластома яичника
Гонадобластома развивается у больных с дисгенезией гонад и наличием в кариотипе У-хромосомы или ее части, чаше болеют девочки и молодые женщины. Течение гонадобластомы сопровождается первичной аменореей, гипоплазией половых органов, признаками вирилизации. Гонадобластома в 1/3 случаев представляет собой двустороннюю опухоль. Ее диаметр варьирует от микроскопического до весьма большого (10 см). Характерным признаком является отложение солей кальция, иногда очень массивное.
Под микроскопом опухоль состоит из двух основных типов клеток - крупных зародышевых, соответствующих элементам дисгерминомы или семиномы, и мелких, напоминающих незрелые клетки Сертоли. Кроме того, в строме обычно обнаруживаются клетки, похожие на клетки Лейдига, однако не содержащие кристаллы Рейнке. Герминогенные клетки имеют крупные размеры, округлую форму, светлую или слегка зернистую цитоплазму и округлое везикулярное ядро с ядрышком. Незрелые клетки Сертоли или гранулезные клетки мельче, они округлые и содержат округлые, овальные или продолговатые ядра. Оба типа клеток формируют гнезда, в которых производные полового тяжа могут располагаться по-разному. Иногда они окружают отдельные зародышевые клетки либо группы зародышевых клеток или же строят корону вокруг гнезд, окружают мелкие круглые полости, содержащие аморфные эозинофильные ШИК (РА5) - положительные массы, образуя подобие телец Колля-Экснера.
VI. Смешанные опухоли из герминогенных клеток и полового тяжа
Смешанные опухоли из герминогенных клеток и полового тяжа включают в себя диморфные новообразования из герминогенных элементов и производных полового тяжа, выявляемые у анатомически, фенотипически и генетически нормальных женщин.
Макроскопически это крупные односторонние округлые или овальные инкапсулированные опухоли. На разрезе обнаруживается серовато-розовая или желтовато-коричневая ткань солидной консистенции, иногда мелкие кисты.
Под микроскопом те же два типа клеток, которые характерны для предыдущей формы, могут сосуществовать в составе трабекулярно-тяжистых структур, округлых гнезд с периферическим расположением производных полового тяжа, центральным расположением герминогенных элементов и беспорядочным расположением герминогенных клеток в различных соотношениях. Иногда эта форма сочетается с дисгерминомой или другими злокачественными герминогенными опухолями.
VII. Опухоль сети яичника
Опухоль сети яичника - групповое обозначение редко встречающихся новообразований, обычно являющихся находкой при разных оперативных вмешательствах. Опухоль может быть верифицирована лишь в том случае, если она находится в области ворот яичника, построена из клеток, не содержащих реснички, и включает в себя сетевидные структуры. Клинически у больных иногда наблюдается вирилизация из-за гиперплазии хилюсных клеток. Макроскопически опухоль может достигать 20 см и более, бывает одно - или многокамерной. Аденома содержит тесно прилежащие друг к другу трубочки, иногда с расширенным просветом и мелкими сосочками.
Аденокаринома - крайне редкая опухоль, которая имеет строение тубулярно-сосочкового рака с участками переходно-клеточного типа.
VIII. Мезотелиальные опухоли
Аденоматоидная опухоль - солидно-кистозное новообразование, возникающее в области ворот яичника и, как правило, имеющее небольшие размеры. Опухоль состоит из трубочек разной формы и размера, выстланных уплощенными или цилиндрическими клетками с бледной вакуолизированной цитоплазмой и небольшими ядрами.
Злокачественная мезотелиома брюшины часто переходит на яичник. Для постановки диагноза собственно мезотелиомы яичника необходимо, чтобы опухоль преимущественно или целиком росла на яичнике и даже проникала глубоко в корковый слой. По микроскопическому строению мезотелиома яичника практически идентична мезотелиоме брюшины.
IX. Опухоли неясного генеза и смешанные опухоли
1.1 Мелкоклеточный рак
А). Мелкоклеточный рак - групповое обозначение, включающее в себя два типа опухолей: мелкоклеточный рак, протекающий с гиперкальциемией; нейроэндокринный тип, аналогичный мелкоклеточному раку легкого. Этой формой болеют сравнительно молодые женщины в возрасте преимущественно до 55 лет.
Макроскопически опухоль имеет крупные размеры, солидную консистенцию, на разрезе желтоватый цвет, кисты, очаги кровоизлияний. Встречаются случаи семейного поражения, при этом наблюдается двусторонний процесс.
Под микроскопом мелкоклеточный рак, протекающий с гиперкальциемией, представлен диффузными разрастаниями мономорфных клеток с узким ободком цитоплазмы и мелкими овальными, округлыми или веретенообразными ядрами с отчетливыми ядрышками. В ряде случаев встречаются солидные поля из крупных клеток с развитой эозинофильной цитоплазмой и крупными ядрышками. В некоторых клетках видны эозинофильные включения ярко-красного цвета.
Иногда можно встретить морфологически доброкачественные железистые структуры с выстилкой из муцинсекретирующих эпителиоцитов, а также мелкие скопления перстневидных клеток. В этой опухоли часто формируются фолликулоподобные структуры, имитирующие таковые в гранулезоклеточной опухоли ювенильного типа. Нейроэндокринный тип мелкоклеточного рака встречается у женщин старшего возраста, живущих до 85 лет и более. Это крупная опухоль солидной консистенции, обычно двусторонняя, на ее разрезе бывают видны кисты. По микроскопическому строению она полностью идентична мелкоклеточному раку легкого, однако может включать в себя небольшие очаги эндометрноидного рака, опухоли Бреннера, опухолей из слизеобразующего или плоского эпителия.
Струма яичника. Карциноид яичника. Гонадобластома яичников.
До последнего времени вопросы гистогенеза опухолей яичников имели преимущественно академическое значение. Теперь, когда арсенал лечебных средств онкогинекологов значительно обогатился противоопухолевыми препаратами, а самое главное, появилось очень перспективное направление — генотерапия, большое практическое значение приобретает установление точного гистогенеза опухоли. Источником почти всех эпителиальных опухолей яичников считаются кисты включения, возникающие в результате отшнурования инвагинированного покровного мезотелия. Клетки в этих кистах могут дифференцироваться в сторону как трубного, так и эндоцервикального эпителия. Клетки герминогенных опухолей развиваются из зародышевых клеток, а стромальноклеточные опухоли яичников из мезенхимальных.
Многие авторы, в течение длительного времени занимающиеся этим разделом онкоморфологии, однозначно признаются в том, что в значительном числе наблюдений установить начало инвазивного роста не представляется возможным. По-видимому, это обстоятельство и привело к выделению в классификации ВОЗ подгруппы так называемых «пограничных» опухолей или "карцином низкой степени злокачественности" (Карселадзе А.И., 1989)
Морфологическая классификация опухолей яичников (ВОЗ, 2002).
- I Эпителиальные опухоли.
- А. Серозные опухоли.
- а) цистаденома;
- б) папиллярная цистаденома;
- в) поверхностная папиллома;
- г) аденофиброма и цистаденофиброма.
- а) цистаденома и папиллярная цистаденома;
- б) поверхностная папиллома;
- в) аденофиброма и цистаденофиброма.
- а) аденокарцинома, папиллярная аденокарцинома и папиллярная цистаденокарцинома;
- б) поверхностная папиллярная карцинома;
- в) злокачественная аденофиброма и цистаденофиброма.
б) аденофиброма и цистаденофиброма.
2. Пограничные (потенциально низкой степени злокачественности):
а) кишечного типа;
б) эндоцервикального типа;
4. Муцинозная кистозная опухоль с интрамуральными узелками;
5. Муцинозная кистозная опухоль с псевдомиксомой брюшины.
В. Эндометриоидные опухоли (в том числе с плоскоклеточной метаплазией):
а) аденома и цистаденома;
б) аденофиброма и цистаденофиброма.
2. Пограничные (потенциально низкой степени злокачественности):
б) аденофиброма и цистаденофиброма.
б) злокачественная аденофиброма и цистаденофиброма;
в) злокачественная смешанная мезодермальная (мюллерова) опухоль
д) эндометриальная стромальная саркома;
е) недифференцированная саркома яичников.
б) эндометриоидная стромальная саркома;
Г. Светлоклеточные (мезонефроидные) опухоли:
б) аденофиброма и цистаденофиброма;
2. Пограничные (потенциально низкой степени злокачественности):
а) кистозная опухоль;
б) аденофиброма и цистадеонофиброма;
б) аденокарцинофиброма (злокачественная аденофиброма);
Д. Переходноклеточные опухоли:
- опухоли Бреннера (метапластический вариант);
- пограничная опухоль Бреннера ( пролиферирующий вариант);
а) переходноклеточный рак;
б) злокачественная опухоль Бреннера.
Е. Плоскоклеточные опухоли:
1. Плоскоклеточный рак;
2. Эпидермоидная киста.
Ж. Смешанные эпителиальные опухоли:
2. Пограничные (пограничной злокачественности).
З. Недифференцированные и неклассифицируемые опухоли:
1. Недифференцированный рак;
2. Аденокарцинома , БДУ.
II Опухоли стромы полового тяжа
А. Гранулезно–стромальноклеточные опухоли:
1. Гранулезоклеточная опухоль.
2. Группа теком фибром:
а) текома типичная, лютеинизированная;
в) клеточная фиброма;
д) стромальная опухоль с элементами полового тяжа;
е) склерозирующая стромальная опухоль;
ж)перстневидная стромальная опухоль;
з) неклассифицируемые опухоли (фибротекома).
Б. Опухоли из клеток Сертоли и стромальных клеток:
Опухоли из клеток Сертоли и Лейдига ( андробластомы):
а) высокодифференцированные ( тубулярная андробластома);
- с гетерологическими элементами;
в) низкодифференцированные (саркоматоидные):
- с гетерологическими элементами;
- с гетерологическими элементами;
д) опухоль из клеток Сертоли;
е) опухоль из клеток Лейдига и стромальных клеток;
В. Смешанные опухоли стромы полового тяжа и неклассифицированные опухоли:
а) опухоли стромы полового тяжа с кольцевидными трубочками;
в) неклассифицированная опухоль стромы полового тяжа;
Г. Стероидноклеточные опухоли:
Опухоль из клеток Лейдига:
а) хилусноклеточная опухоль;
б) опухоль из клеток Лейдига нехилусного типа;
в) опухоль из клеток Лейдига, БДУ*;
Стероидноклеточная опухоль , БДУ*:
б) злокачественная. 9
III Герминогенные опухоли.
А. Примитивные герминогенные опухоли:
2. Опухоль эндодермального синуса (опухоль желточного мешка):
а) поливезикулярная вителлиновая опухоль;
б) железистый вариант;
в) гепатоидный вариант.
3. Эмбриональный рак;
6. Смешанная герминогенная опухоль.
Б. Двухфазная и трехфазная тератома:
б) зрелая: солидная, кистозная (дермоидная киста), эмбрионоподобная тератома
В. Монодермальные тератомы (высокоспециализированные) и опухоли,
развивающиеся на фоне дермоидных кист:
а) струма яичника; доброкачественная и злокачественная;
г) струмальный карциноид;
2. Нейроэктодермальные опухоли:
б) примитивная нейроэктодермальная опухоль;
3. Эпителиальные опухоли:
а) плоскоклеточный рак ;
б) невоклеточный невус.
6. Опухоли сальных желез:
а) аденома сальных желез;
б)рак из сальных желез;
7. Гипофизарные опухоли.
8. Опухоли из закладок сетчатки;
9. Другие опухоли.
IV. Опухоли , состоящие из элементов герминогенных опухолей и опухолей стромы
а) с элементами злокачественной герминогенной опухоли;
2.Смешанная герминогенная опухоль и опухоль стромы полового тяжа:
а) с элементами злокачественной герминогенной опухоли.
V. Опухоли мягких тканей, неспецифичные для яичников.
VI. Неклассифицированные опухоли.
VII. Вторичные (метастатические) опухоли.
VIII. Опухолевидные процессы:
а) лютеома беременности.
б) гиперплазия стромы яичника и гипертекоз.
в) массивный отек яичника.
г) единичная фолликулярная киста и киста желтого тела.
д) множественные фолликулярные кисты (поликистозные яичники).
е) множественные лютеинизированные фолликулярные кисты и (или) желтые тела.
з) поверхностные эпителиальные кисты включения (терминальные кисты
и) простые кисты.
к) воспалительные процессы.
л) параовариальные кисты.
*БДУ-без дополнительных указаний.
Степень распространения, а соответственно, и стадию болезни устанавливают на основании данных клинического обследования, результатов оперативного вмешательства и гистологического изучения биоптатов, взятых во время операции из различных участков брюшной полости. Правильное определение стадии болезни позволяет выбрать оптимальную тактику лечения и улучшить результаты лечения. Классификация РЯ по стадиям ( UICC, 6 издание,2002 ) приведена ниже .
Новообразования яичников и матки у девочек
К новообразованиям яичников и матки относят доброкачественные и злокачественные опухоли, растущие из ткани яичника и матки. К опухолевидным образованиям или кистам яичников – образования, образующиеся за счет накопления жидкости в полости.
В структуре гинекологической заболеваемости детей и подростков удельный вес опухолей и опухолевидных образований яичников и матки колеблется от 1 до 4,6%. При этом опухоли и кистозные образования яичников составляют около 40% от числа новообразований органов брюшной полости, уступая по частоте лишь опухолям печени. По частоте встречаемости первое место занимают опухолевидные образования яичников (40-50% случаев), второе и далее ― истинные доброкачественные образования яичников (ДОЯ) (герминогенные, эпителиальные, гонадобластомы).
![]()
Новообразования яичников встречаются у детей всех возрастов, однако процент их выявления увеличивается в период полового созревания (10–14 лет), что подтверждает роль гипофизарной стимуляции в этиологии этих новообразований.
Чаще всего пациентки предъявляют жалобы на боль в нижних отделах живота различного характера и интенсивности. У пациенток могут быть нарушение менструального цикла вплоть до прекращения менструаций, либо по типу нерегулярных и/или болезненных менструаций, кровотечений. Однако необходимо учесть, что примерно у 20% девочек опухоли и опухолевидные образования яичников протекают без каких-либо клинических проявлений и бывают случайной диагностической находкой. В связи с частым бессимптомным течением заболевания, профилактические осмотры гинекологом детского и юношеского возраста являются эффективным способом выявления опухолей яичников и матки у девочек на ранних стадиях.
Гормональноактивные опухоли яичников могут проявляться преждевременным половым созреванием.
В случае перекручивания или разрыва, кровоизлияния в кисту или опухоль яичника, при возникновении воспаления возможно развитие клиники острого живота (острая боль в животе, с иррадиацией чаще всего в промежность, температура, тошнота, рвота, иногда задержка стула, мочеиспускания) вплоть до развития шока, обусловленного внутрибрюшным кровотечением и попаданием содержимого яичникового образования в брюшную полость. При этом необходимо иметь в виду, что среди причин, вызывающих развитие клинической картины «острого живота» у детей, перекручивание яичников и новообразований придатков составляет около 15%, что гораздо чаще, чем у взрослых в связи с анатомо-топографическими и физиологическими особенностями детского организма.
Диагностика объемных образований яичников и матки у девочек основана на оценке клинико-анамнестических данных, ректоабдоминального обследования, УЗИ органов малого таза с проведением ЦДК с оценкой кровотока в матке и придатках, при необходимости – МРТ органов малого таза, определения уровня онкомаркеров и гормонов.
Функциональные кисты яичника часто подвергаются обратному развитию в течение 3 - 4 месяцев и подлежат консервативному ведению.
Показания к госпитализации: при наличии симптомов «острого живота», при подозрении на перекручивание ножки опухоли и/или яичника, разрыв или надрыв капсулы кисты, нагноение, кровоизлияние в стенку или полость опухоли необходима экстренная госпитализация. Госпитализация показана всем пациенткам с образованиями яичников, подлежащими оперативному лечению. Предпочтение при оперативном лечении по поводу новообразований яичников и матки отдают лапароскопическому доступу и максимально органосохраняющим операциям.
Читайте также:
- Зрелые:
- Доброкачественные:
- Серозные опухоли